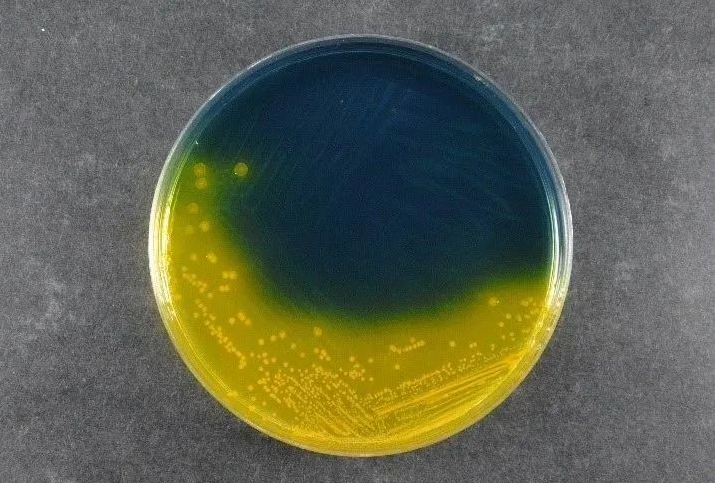
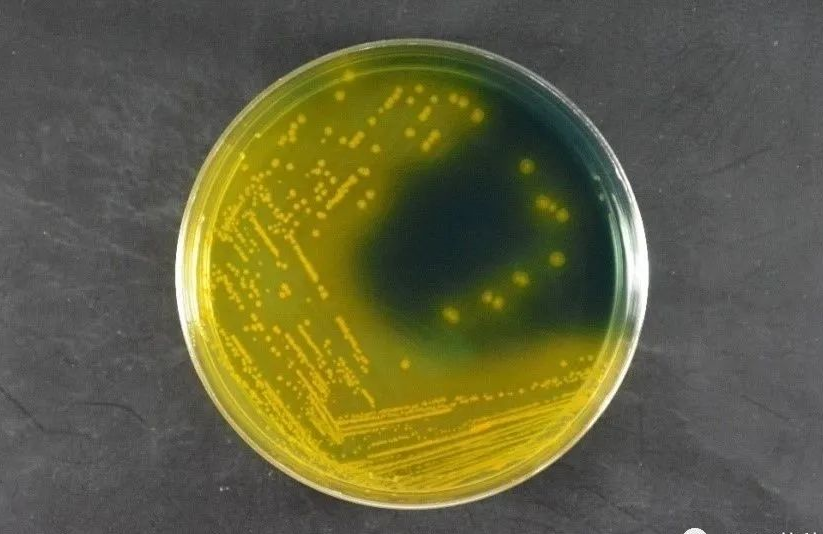
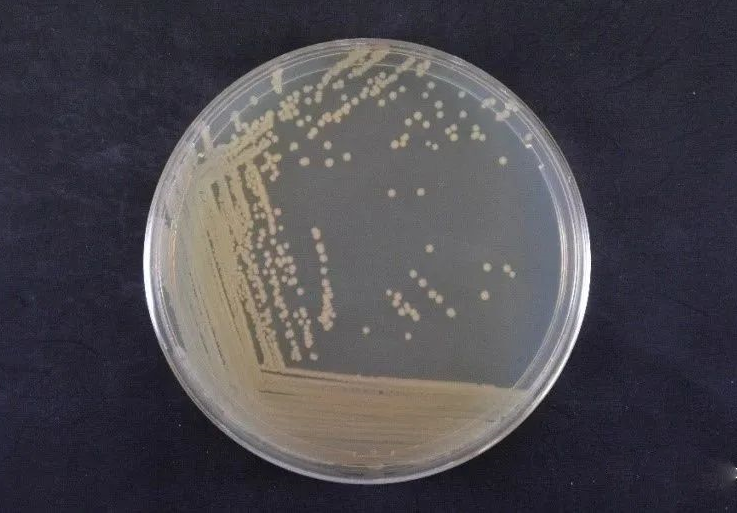

海博微信公众号
海博微信公众号
 海博天猫旗舰店
海博天猫旗舰店


 海博微信公众号
海博微信公众号
 海博天猫旗舰店
海博天猫旗舰店




创伤弧菌Vibrio vulnificus是一类来源于海洋的嗜盐性革兰氏阴性细菌,俗称“海洋杀手”,广泛存在于虾、螃蟹、鱼、牡蛎等海产品中,可引起人类急性肠胃炎、坏疽性伤口感染及败血症等疾病。2020年10月GB 4789.44-2020《食品安全国家标准 食品微生物学检验 创伤弧菌检验)》正式发布,并将于2021年3月11日开始实施正式颁布实施。
作为食品安全检测中新增的一类致病菌,在检测过程中了解并使用创伤弧菌标准菌株,对帮助检测人员正常识别创伤弧菌与保证检测结果的准确性和可靠性具有重要的意义。此外,在标准中也要求实验室在PCR初筛和PCR鉴定阶段“使用创伤弧菌标准菌株作为阳性对照”。
形态学

3%NaCl胰蛋白胨大豆琼脂(TSA)培养基,36±1 ℃培养18 h,菌体弧状,长短不一,单个排列,革兰氏阴性。
纤维二糖-多粘菌素E琼脂(CC)培养基,36±1℃培养18h,菌落黄色,圆形、扁平
光照下中心不透明但边缘透明,菌落周围有黄色晕圈,直径1mm~2mm。
改良纤维二糖-多粘菌素-多粘菌素E琼脂(mCPC)培养基,36±1℃培养18h,菌落黄色,圆形、扁平
光照下中心不透明但边缘透明,菌落周围有黄色晕圈,直径1mm~2mm。
3%NaCl胰蛋白胨大豆琼脂(TSA)培养基,36±1℃培养18h,菌落圆形,乳白色,湿润,凸起,表面光滑,直径1mm~2mm。
关键生化特性
|
氧化酶 |
+ |
|
动力 |
+ |
|
赖氢酸脱羧酶 |
+ |
|
蔗糖 |
- |
|
葡萄糖 |
+ |
|
D-纤维二糖 |
+ |
|
乳糖 |
+ |
|
V-P |
- |
|
ONPG |
+ |
|
嗜盐性实验 |
|
|
NaCl含量0% |
- |
|
NaCl含量6% |
+ |
|
NaCl含量8% |
- |
|
NaCl含量10% |
- |


嗜盐性试验:3%NaCl含量

3%氯化钠三糖铁琼脂穿刺试验:底层产酸变黄,不产硫化氢,不产气
2株创伤弧菌标准菌株PCR鉴定结果

a:DNA Marker; b:创伤弧菌CICC 10383; c:创伤弧菌CICC 21615;d:副溶血弧菌CICC 21617; e:空白对照; f:DNA Marker
PCR鉴定结果显示,创伤弧菌CICC 10383和CICC 21615含有vvhA基因,大小为519bp,可以作为PCR阳性对照副溶血弧菌CICC 21617 不含有vvhA基因,可以作为PCR阴性对照。
本文转载自微信公众号CICC菌种平台
上一篇:臂微菌属内种的描述之游离臂微菌
下一篇:突柄微菌属种的描述之水生突柄微菌



